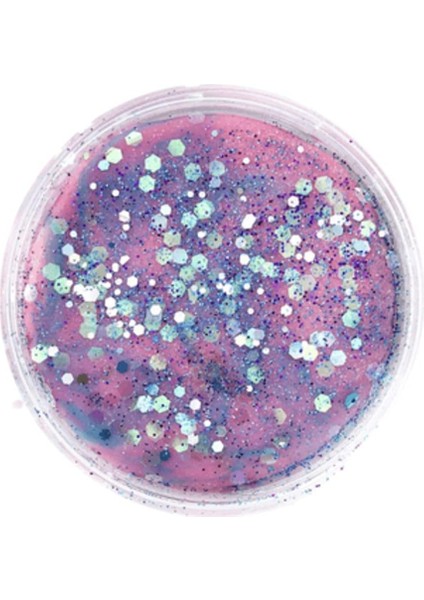

Pearl Shop Comica Dough Tekli Doğal Oyun Hamuru - Sweet Sparkle 130GR
Henüz değerlendirilmemişİlk sen değerlendir
Satıcı: Pearl Shop
9,1
9,1Satıcı puanı
Satıcı puanı, müşteri geri bildirimleri ve satıcının sipariş sürecindeki performansı dikkate alınarak hesaplanmaktadır.Ürün Bilgileri
Yurt Dışı Satış
Yok
Stok Kodu
HBCV0000AKBF6N
Stok Adedi
50 adetten az
Comica Dough Tekli Doğal Oyun Hamuru - Sweet Sparkle 130GR
marka: Mamma comicaÜrün özellikleri
Yurt Dışı Satış
Yok
Stok Kodu
HBCV0000AKBF6N
Stok Adedi
50 adetten az
Hatalı içerik bildir
Popüler Aramalar
squishyoyun hamuru kalıplarıkil hamurulego zombikilkurumayan oyun hamuruzıplayan hamurköpük hamuroyun hamuru şekillerislime oyun hamuruplay doh 4lü oyun hamuruoyun kumutransformers optimus prime oyuncakplastilinlego zombi çeşitleri & fiyatlarıfisher price legooyuncak telefonuçar oyuncak magic blocksmantar tabancasıilk adım arabası